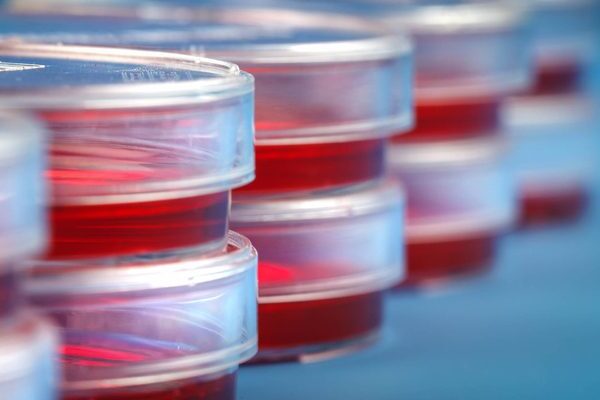

- Home
- Lab Tests
- Test Categories
- Health Packages
- Cardiac Screening Test Package
- Advance Base Line Package
- Cancer Diagnosis Tests | Tumor Marker Test Package For Females
- Cancer Diagnosis Tests | Tumor Marker Test Package For Males
- Diabetes Health Test Package
- General Affordable Health Test Package
- Infertility Screening Tests Package (Women)
- Iron Profile for Iron deficiency (ANEMIA)
- Joints Pain Tests Package
- Nutritional Deficiency Test Package
- Polycystic Ovary Syndrome (PCOS) Test Package for Women
- Special International Travel Test Package
- About us
- Online Reports
- Collection Center
Lab Tests
You are here:
- Home
- Lab Tests